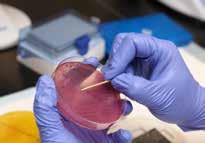

CityU veterinary and biomedical scientists join hands to tackle








As the acting Dean of the Jockey Club College of Veterinary Medicine and Life Sciences, I would like to welcome you to another edition of Critters, our in-house newsletter which strives to keep our worldwide audience up to date with the fast developing pace of our vet college as well as our biomedical and neurosciences departments. Certainly the last half year has been an extremely 'interesting' period both for our students and faculty and staff. The resilience of our students in the face of social unrest and now Covid-19 has shown them to be both robust and mature, characteristics that should bode well for them in their working life.
With our third cohort of BVM students and a growing number of students major in biomedical and biological sciences, as well as a substantial number of graduate students, the college continues to strive forward in leaps and bounds. The CityU Veterinary Medical Centre (CityU VMC) and Veterinary Diagnostic Laboratory continue to perform well and offer new services (such as the new oncology specialist service at CityU VMC) and our Department of Veterinary Clinical Science will be established soon by Professor Julia Beatty (see the story about Professor Julia Beatty and Professor Vanessa Barrs in this issue). You will also hear from Professor Bruce Ransom, the head of the Department of Neuroscience, the newest department in JCC.
These are trying times around the globe but at the heart of every solution to major problems is education and action. We will continue to do our part in ensuring that the world emerges from these issues with renewed vigour and enthusiasm. Enjoy!
Professor Michael Yang Acting Dean
身為賽馬會動物醫學及生命科學院署理院長,我誠邀大家閱讀新一 期《Critters》,這份學院通訊讓世界各地的讀者了解我們獸醫課程 與生物醫學系及神經學系的蓬勃發展。過去半年,我們的學生與教 師們經歷前所未有的挑戰,我感受良多。一班學生本已身處社會動 盪之中,如今新型冠狀病毒更證明,唯有練得堅強成熟,才是踏足 社會的最好準備。
隨著第三屆獸醫學士學生於2019年入學、生物醫學和生物科學學生 愈來愈多、研究生數目不斷增長,賽馬會動物醫學及生命科學院日 漸壯大,正在蓬勃發展。城大動物醫療中心和城大動物醫療檢驗中 心成績斐然,提供更多服務(如城大動物醫療中心的腫瘤科服務), Julia Beatty教授(見今期Beatty教授和Barrs教授專訪)領導的 臨床動物醫學系也快將成立。在今期的《Critters》,您也可以加深 對我們最新學系神經科學系主任Bruce Ransom教授的認識。
世界雖然正值艱難時期,但所有重大問題的解決方法,關鍵始終是 教育和行動。我們會繼續堅守崗位,熱情投入,與大家一同努力確 保社會渡過重重難關。
CityU veterinarians join forces with the livestock industry to fight antimicrobial resistance


Biomedical graduates turned disease detectives 生物醫學系畢業生變身疾病偵探
JCC biomedical scientist discovers in vivo primings
城大生物醫學家研發體內啟動
A Ray of Hope for Cancer Patients: High-Accuracy New Blood Test to Detect Cancer Cells

癌症病人救星:癌症血液檢測技術
When Veterinary Curriculum and Food Industry professionals work together 獸醫課程連結食品工業專家
CityU VDL: making a significant contribution to animal disease investigation in Hong Kong 城大動物醫療中心 偵查香港動物疾病

World renowned Feline Veterinarians join JCC: Professor Vanessa Barrs and Professor Julia Beatty
學院新人事 澳洲貓科權威 Vanessa Barrs教授 Julia Beatty教授
Professor Bruce Ransom sets up new Neuroscience department at CityU
權威學者Bruce Ransom教授為城大成立神經學系
Introducing Dr. Dai Koyabu Associate Professor in Comparative Anatomy
介紹小藪大輔博士 比較解剖學副教授
Introducing our newly appointed Assistant Professor in Animal Behaviour and Welfare
Dr. Kai Liu
新任動物行為及福利助理教授劉凱教授 以新禽畜圈舍改善動物福利
Editor-in-Chief: Dr Howard Wong
總編輯:王啟熙獸醫
Editor: Bonnie Chu
編輯:朱翠珊
Doom and gloom has enveloped Hong Kong since the start of 2020. A new coronavirus, designated SARSCoV-2, has swept Hong Kong, with newly confirmed cases reported each day. People have often been seen stocking up on surgical masks and exchanging ideas on social media on how to stay safe. As medical experts begin research on vaccines to deal with the novel coronavirus, the Jockey Club College of Veterinary Medicine and Life Sciences (JCC) is also standing at the forefront, its veterinary and biomedical scientists ready to fight the epidemic together with the Hong Kong people.
This current health crisis calls to mind the Severe Acute Respiratory Syndrome (SARS), which ravaged Hong Kong in 2003 and which remains deeply entrenched in the psyche of Hong Kong people. While SARS was thought to be passed to people from palm civet cats, which had themselves been infected by a chain of animals with an origin in bats, the novel coronavirus is believed to have possibly originated from wild animals sold at a seafood market in Wuhan, where according to some Chinese experts, pangolins may have acted as the intermediate host. As the only veterinary medicine college in Hong Kong, JCC and its experts are contributing to collective efforts to combat this emerging and zoonotic infectious disease on all fronts.



Professor Sheng Chen, Department of Infectious Diseases and Public Health and JCC’s Associate Dean (Research), is a leading scholar in biomedical sciences. Being actively involved in medical research related to pneumonia, he started to investigate the outbreak in its initial stage. He utilized the whole genome sequence of COVID-19 to perform comparative genetic and functional analysis of the human SARS virus and coronaviruses recovered from different animals. Phylogenetic analysis of the coronavirus in different species indicated that COVID-19 is a new type of bat coronavirus.

“These data is important to guide the design of infection control policy and inform the public on the nature of the threat of COVID-19, which helps to control further dissemination of this new coronavirus, and allows us to develop rapid tests and vaccines.” Professor Chen said.

An emergency response policy is essential to tackling the disease, especially since a solution to the novel coronavirus has not yet been found. As such, Dr Sean Yuan Hsiang-yu, Assistant Professor in the Department of Biomedical Sciences, has contributed his expertise through developing a meta population model for the comparison of different disease control policies. In January, he estimated that the worstcase scenario for a novel coronavirus outbreak in the local community could be more than 220 individuals infected, when 300,000 Hong Kong residents return from the mainland after the Chinese New Year holidays.
Dedicated to transferring knowledge from basic science to public health policy, Dr Yuen pointed out the need for at least 410 quarantine beds for imported cases and secondary locally infected cases. His advice shed light on the disease control measures implemented in Hong Kong at this early stage.
Meanwhile, Hong Kong pet owners are also concerned about the novel coronavirus as they live closely with their beloved companions. JCC veterinary medicine experts were keen to clear up rumours and confusion using their own expertise.
Professor Julia Beatty, Chair Professor of Veterinary Medicine and Infectious Diseases and Professor Vanessa Barrs, JCC's Associate Dean, Chair Professor of Companion Animal Health and Disease, both from the Department of Infectious Diseases and Public Health pointed out that among the different coronaviruses, dogs and cats are most commonly infected by alpha coronaviruses, including feline coronavirus and canine coronavirus. These viruses only infect cats and dogs, do not typically cause pneumonia and are different to the Beta Coronaviruses that include SARS, Middle East Respiratory Syndrome (MERS) and SARS-CoV-2.
“There are many causes of fever, sneezing and coughs in cats and dogs. In cats, common causes of these symptoms are two different respiratory viruses unrelated to coronaviruses. In dogs kennel cough is also common and is caused by bacteria and viruses unrelated to coronaviruses,” said Professor Barrs.

Pet owners should continue to take normal precautions such as washing hands after handling pets. There are rumours of some owners abandoning their pets because of their concern for human safety, but such fears are misplaced. It is very important for owners to understand that there is no evidence that humans can contract Covid-19 from pets.

Looking back, evidence from SARS, avian influenza and Covid-19 provides a clear indication that the health of animals, humans and the environment are interrelated, says Professor Dirk Pfeiffer, Chow Tak Fung Chair Professor of One Health.

“Due to my cultural background, I find it difficult to understand why someone would prefer meat from freshly slaughtered animals, nor do I understand what health benefits could come from eating exotic animal meats. Because of my personal biases I am not in a position to judge right and wrong. That’s why I firmly believe that we need to first understand the reasons for these behaviours.”
As we live in an increasingly connected society with ever increasing human mobility, experts at JCC are dedicated to developing a timely emergency response at the beginning of an epidemic. Their goal is also to contribute to building a healthy society based on the principles of One Health in order to reduce the future emergence of zoonotic infectious diseases, thereby creating a safer and more secure future for everyone.



踏入2020年,香港社會有點躁動不安。源於新型冠狀病 毒的新冠肺炎的本地感染個案一直增加,人們爭相搜羅口 罩,在網上討論抗疫良方。當人類醫生正在鑽研疫苗,香 港城市大學賽馬會動物醫學及生命科學院也身在最前線, 學院一班獸醫及生物醫學專家攜手與港人共同抗疫。
這次疫情令人回想2003年俗稱「沙士」的嚴重急性呼吸 系統綜合症,至今香港人猶有餘悸。沙士源於人們進食了 感染蝙蝠洞病毒的果子狸,今天新冠肺炎則可能源於武漢 海鮮市場售賣的野生動物,內地專家指出穿山甲是新型冠 狀病毒的中間宿主。賽馬會動物醫學及生命科學院作為香 港唯一動物醫學院,團隊中各方專家在不同崗位為應對這 個新興人畜共患傳染病各盡其力。
賽馬會動物醫學及生命科學院副院長(研究)、公共衛生學 系教授陳聲教授為生物醫學權威,過往多次參與肺炎及相 關藥物的研究,他早於疫症初期便着手研究。他利用新型 冠狀病毒的全基因組序列,比較人類沙士病毒及動物曾患 的冠狀病毒的基因及功能分析。各種冠狀病毒的種系發生 分析顯示,2019新型冠狀病毒是一種新型蝙蝠冠狀病毒。
陳教授說:「這些數據有助制訂預防感染政策,向公眾解 釋2019新型冠狀病毒的威脅,從而控制疫情繼續蔓延, 以及推出快速測試方法及疫苗。」
當全球均對新型冠狀病毒束手無策,推出及時應變政策對 抗疫起着關鍵作用。因此生物醫學系助理教授阮相宇博士 則以複合種群模式為政府出謀獻策。他早於1月推算新型 冠狀病毒在農曆年假期結束後的社區爆發風險,若以最壞 情況作估算,假設有30萬人從內地返港,有機會增加至 220多人受感染。
阮博士多年來致力將基礎科學的知識轉移至公共衛生政策,他 基於以上的評估數據,建議政府在第一波及第二波感染期間, 總共要預備410張隔離床位,為香港的抗疫措施帶來新的啟 示。
很多香港人跟寵物形影不離,寵物主人對新冠肺炎也聞之色 變,賽馬會動物醫學及生命科學院的相關專家樂於以自己的專 業知識為寵物主人逐一解難。
動物醫學及傳染病講座教授Julia Beatty及賽馬會動物醫學及 生命科學院副院長、伴侶動物健康及疾病講座教授Vanessa Barrs,指出冠型病毒有數以百種,會感染貓狗的大多是甲型 冠型病毒,包括貓科冠狀病毒及狗科冠狀病毒,這類病毒只會 感染貓和狗,但不會引發肺炎,跟導致沙士、中東呼吸綜合症 (MERS)及新冠肺炎的第二組冠型病毒不同。
他們說:「貓狗發燒、打噴嚏及咳嗽的原因繁多,如果貓出現 這些病徵,大多因為兩種不同的呼吸道病毒,跟冠狀病毒無 關。至於狗隻常見的犬舍咳則由細菌和病毒引起,亦跟冠狀病 毒無關。」
寵物主人應採取如常的保護措施,例如接觸寵物後洗手。坊間 出現謠言,引致某些寵物主人因擔心個人安全而棄養自己的寵 物,這些恐懼均是毫無根據。各位寵物主人必須明白,沒有已 知的風險顯示人類會從寵物身上感染2019新型冠狀病毒。
回頭一看,從沙士、禽流感、非洲豬瘟到2019新型冠狀病毒, 都證明動物、人類和環境健康息息相關,因此周德豐講座教授 Dirk Pfeiffer教授一直致力推動「健康一體化」。
他舉例說:「基於我的文化背景,我難以理解何以有人喜歡吃 新鮮屠宰的肉類,也無法明白野生動物有何益處。由於我在這 方面有先入為主的看法,我不宜去判斷當中對錯,因此我更深 信應該先了解這類行為的因由。」
當我們的社會愈來愈密集,人類流動愈來愈頻繁,賽馬會動物 醫學及生命科學院一眾專家不單在疫症爆發之初尋覓緊急應變 措施,也致力為建造一個長遠的健康一體化社會出一分力,減 少人畜共患症的危機,為大家締造更安全可靠的未來。
According to the United Nations Ad Hoc Interagency Coordinating Group on Antimicrobial Resistance, 700,000 people die from diseases related to antimicrobial resistance (AMR) every year, of which 230,000 are killed by multi-resistant tuberculosis. By 2050, more than 10 million people will have perished from these types of illnesses, posing a serious threat to the global economy.
Just as experts from around the world strive to tackle the issue, the Jockey Club College of Veterinary Medicine and Life Sciences (JCC) initiated AMR research projects on local pig farms, poultry farms and fish farms in 2019, with three grants totalling HK$35-million provided by the Sustainable Agricultural and Fisheries Development Fund managed by the Agriculture, Fisheries and Conversation Department. The projects aim to enhance industry sustainability by improving its operation and reducing antibiotic use.


One of these 2-year projects, “Improving Pig Health and Production in Hong Kong” received a HK$15million grant. A team of 3 veterinarians including Dr. Lee Song Hao from Singapore and Dr. Michael Wilson from Australia, led by Assistant Professor Friederike Zeeh, provides free consultation service to local pig farms.

There are currently 43 licensed pig farms in Hong Kong. Dr Lee said the team has actively engaged with these farms over the past year, advising them on improving the environment on the farm, streamlining farm operations, and boosting the health of pigs. He said, “The pig industry has mostly been comprised of family businesses. Most of them have always relied on their own farming techniques instead of consulting veterinarians, which were simply not available before. We have to build trust with them as part of our provision of veterinary services.”
The two veterinarians recently visited a pig farm in Lau Fau Shan, Yuen Long, together with two veterinary technical assistants Choi Sze Chun and Lam Po Kin. 3,500 pigs in the farm are kept in different pig sheds depending on their age. “Some pig farmers would use antibiotics, but this is only effective for treating bacterial diseases and even then, the right antibiotics must be used in the right doses for the right duration. To get to the root cause of the problem, we should focus instead on improving animal welfare and keeping pigs healthy.”
The owner of one of the pig farms, Mr Lam, has been steadily improving the enclosed environment on his farm by installing ventilation and cooling devices. He said, “In the past, we could only conjecture the cause of death in pigs based on our experiences. Now CityU veterinarians can perform autopsies to investigate the cause of death. In a time when African swine fever is raging through the region, CityU has definitely helped us to prevent the disease from entering our local farms.”
The veterinary team will also examine the efficacy of vaccines and antibiotic in pigs by taking clinical samples from pigs, such as blood and faeces.


The use of antibiotics is recommended only when the pigs are ill due to bacterial infections. “Some antibiotics used are fourth generation but excessive use may lead to increased antibiotic resistance. Therefore, we have to examine the antimicrobial susceptibility of a pathogen to decide if we can use second or third-generation antibiotics, reducing the impact of AMR on both society and livestock.”
Dr Li said that the team is also establishing a pharmacy department, providing one-stop shop services to pig farms and improving the industry’s use of antibiotics, which will benefit human health in the long run.
Another one of JCC’s projects, “Improving Poultry Health and Production in Hong Kong” led by Dr Yau Hok Ying and Dr Tong Long Ning, also received 15 million dollars in grants. Dr Tong said the use of antibiotics in the livestock industry will be more closely regulated by the government by the end of 2020, which will include the cessation of the existing antibiotics licenses in the industry. He explained, “By then, farmers will need veterinarians’ diagnoses and prescriptions for using antibiotics. These farmers might have been reluctant to employ expensive veterinarians in the past, but with support from government funds through our veterinarians, they will no longer need to worry.”
While his team of 2 veterinarians will regularly visit the 28 licensed chicken farms in Hong Kong, the chicken farms will also regularly provide clinical blood samples from chickens to the CityU laboratory. Dr Yau said chicken farmers are happy with the project and 70% are willing to cooperate. “Clinical blood samples will be collected three times between the time they are born and sold, a period of about 2-3 months. Those samples will help us determine the state of AMR and health condition of the chickens,” he said.
根據聯合國特設跨界別抗菌素抗藥性協調小組報告,每年 最少70萬人死於抗藥性疾病,當中23萬人死於對多種藥 物呈抗藥性的結核病,到2050年,因此死亡的人口更會 突破1000萬人,嚴重衝擊全球經濟。
各國專家竭力出謀獻策,賽馬會動物醫學及生命科學院亦 於2019年初,獲漁農自然護理署旗下的農業持續發展基 金及漁業持續發展基金撥款近港幣3500萬元,推展三項 針對豬隻、家禽及魚類養殖業的抗菌性研究,協助業界改 善作業方式,減用抗生素,促進業界的可持續發展。
三項研究項目皆為期兩年,其中「改善香港豬隻健康及生 產」項目獲撥款港幣1500萬元。學院蘀赫助理教授率領 的三人獸醫團隊為本港豬場提供免費顧問服務,成員包括 來自新加坡及澳洲的李松浩獸醫與麥克爾‧威爾遜獸醫。
香港現有43個持牌豬隻養殖場,李獸醫指團隊過去一年 積極與業界交流,了解豬場的環境、作業模式、豬隻健康 狀況等,再提供改善建議。「以往養豬業界傾向家庭式作 業,根本不會有外聘獸醫,各有飼養方法,我們先要獲得 業界信任,慢慢提供支援服務。」他說。
早前,兩位獸醫與兩位獸醫技術助理蔡詩俊及林溥乾到訪 元朗流浮山的豬場,飼養近3,500百隻豬,按年紀在不同 豬舍圈養。李獸醫說:「很多場主會為豬隻打抗生素,但 抗生素只對病菌引起的病有效,還要配合適當的劑量和服 用期,所以我們要先從這個問題着手,改善動物福利,令 豬隻減少染病。」
其中一個豬場的場主林先生為改善豬舍為密封式設計,加 裝可通風降溫的水簾裝置,他說:「以往豬隻離奇死亡, 我們只能靠經驗推測死因,如今城大獸醫會為豬隻解剖, 追查死因。近期非洲豬瘟肆虐,更要做好防護。」
獸醫團隊還會抽取豬隻的血液和糞便等臨牀樣本,檢驗疫 苗和抗生素對豬隻疾病的成效。
如果豬隻因細菌感染而患病,獸醫才會建議使用抗生素, 「部分抗生素已推出至第四代,藥效最高,但過度使用易 令病菌產生抗藥性,所以我們先測試豬隻病原體的病菌抗 藥性,有時只用第二或第三代已有效,減少抗藥性對社會 和禽畜的影響。」李獸醫說。
李松浩透露團隊正籌建專為香港禽畜業界而設的藥劑部 門,為豬場提供一站式服務,逐步改善業界使用抗生素的 方式,長遠為人類健康把關。
學院另一個獲農業持續發展基金撥款港幣1500萬元的研 究項目,由家禽獸醫唐朗寧及丘鶴英推行「改善香港家禽 健康及生產」研究。唐獸醫指,香港政府將於2020年底 提高對禽畜業界使用抗生素的監管,包括收回業界現有的 抗生素許可證,「屆時業界用抗生素要經獸醫診斷及處方, 以往未必有資金聘請全職獸醫,如今有政府撥款,學院的 獸醫可以填補業界需求。」
他們帶領的兩人獸醫隊會定期走訪全港28個持牌雞隻養 殖場,雞場會定期向城大實驗室主動提供雞隻的臨牀血液 樣本。丘獸醫指業界反應正面,七成半雞場願意合作。他 說:「雞隻由出生到出售兩至三個月間,我們會採集三次 血液樣本,檢驗雞隻的抗藥性問題及健康狀況。」



Interest in fish and fish health has been growing over the last couple of years in Hong Kong because of concerns about food safety. CityU is playing a major role in this drive to safeguard health for aquaculture.

In fact, there have been calls to support the existing marine fish culture and environment. The government explicitly noted in its policy address in 2017 that greater support was crucial for developing the local fisheries industries.
CityU shares the same aims as the government in this endeavour. One notable project along these lines is a twoyear research led by Professor Sophie St-Hilaire, Acting Head of the Department of Infectious Diseases and Public Health at the Jockey Club College of Veterinary Medicine and Life Sciences.
The project “Improving Fish Health and Production in Hong Kong”, which works towards the long-term development of local aquaculture, has secured solid funding from the government. It received a HK$5 million fund from the Sustainable Fisheries Development Fund under the Agriculture, Fisheries and Conservation Department (AFCD).
The primary focus is providing fish farmers and veterinarians with vital health-related information about their fish stocks through workshops and consultations held by Professor StHilaire’s team.
“Experts are invited to talk about specific topics such as water quality and pond management,” Professor St-Hilaire says. “We also run other health-related research projects funded through this grant on fish disease issues and fish disease control strategies.”

Professor St-Hilaire moved to Hong Kong to establish an aquatic veterinary programme at CityU that could address the fish health issues in the region. With the help of AFCD funding she has been able to create an ambulatory service to help Hong Kong fish farmers control and prevent disease outbreaks. The public service has grown over the last two years and now includes two part-time veterinarians and two fish health technicians who visit farms and assist

farmers five days per week. The cost of the site visits is fully covered by the AFCD Sustainable Fisheries Development Fund. The team also gives workshops to farmers on an as-needed basis, and conducts applied field research to address current fish health concerns. Aquaculture research projects initiated through this programme in 2020 include 1) the assessment of mitigation strategies for poor water quality in fresh water ponds, 2) a disease outbreak investigation of mullet summer disease, and 3) a clinical trial for sea lice treatments on salt water net pens.
The response from fish farmers has been very positive. “Our clients are happy with our service. We are dedicated to helping them find sustainable solutions to increase profitability,” Professor St-Hilaire says.
Professor St-Hilaire’s team works closely with the government to support the AFCD’s fish health inspection programme. When the AFCD refers a client in need of veterinary assistance for fish diseaserelated problems, her team promotes the AFCD’s free screening programmes for new fish stocks. In return, her team relies on the AFCD for screening for viral pathogens listed by the World Organisation for Animal Health (OIE). Such efforts enhance productivity in the long run.
The aquatic ambulatory services also provide students
on CityU’s Bachelor of Veterinary Medicine (BVM) programme numerous opportunities to enhance their career prospects.
“This project offers students the chance to shadow fish veterinarians at local farms and help manage cases related to fish disease investigation and fish health management. A clinical rotation in fish medicine is scheduled for the final year of the BVM programme, beginning in 2023,” Professor St-Hilaire says.


Working with the government, CityU is dedicated to ensuring healthier fish and ultimately a more sustainable fish rearing environment.


近年大眾關注食物安全,對魚類健康的關注亦隨之上升。 城大在推動養殖魚類健康這個議題上擔當重要角色。
政府在2017年施政報告中明確表示,致力促進本地漁業發 展;同時,社會上亦有人呼籲支持本港的海魚養殖及環境。
城大與政府在這方面目標一致,由賽馬會動物醫學及生命 科學院傳染病及公共衞生學系署理系主任沈藹莉教授領導 的一個兩年研究計劃,就是一個例子。
這個研究計劃名為「改善香港魚類的健康與生產」,旨在 協助本地水產養殖業長遠發展,獲香港漁農自然護理署 (漁護署)轄下的漁業持續發展基金撥款500萬港元。
沈藹莉教授的團隊主要通過研習會及諮詢服務,為漁民及 獸醫提供養殖魚類的重要健康資訊。
她表示:「我們邀請專家主講有關水質及魚池管理等專題 講座,並運用這筆撥款支持其他與魚類疾病及其控制策略 等健康相關的研究項目。」
沈藹莉教授移居香港後,在城大推行一項水產動物醫學計 劃,協助解決區內的魚類健康問題。通過漁護署的撥款, 她為香港漁民設立魚類護理服務,協助他們控制及防止魚 病爆發。有關服務已推行兩年,現
健康技術員,每周五天探訪漁場及協助漁民。探訪漁場的 費用,由漁護署漁業持續發展基金的撥款支持。沈藹莉教 授的團隊亦按需要為漁民舉辦研習會,並就現有的魚類健 康問題作實地應用研究。團隊將於2020年進行以下水產 養殖研究項目:1) 評核淡水魚塘惡劣水質的改善措施;2) 調查鯔魚夏季疾病;3)就鹹水網欄上的海蝨治理問題作臨 床試驗。
漁民對沈藹莉教授的計劃反應良好。「客戶很滿意我們的 服務。我們致力為他們找出可持續發展的方案,以增加盈 利。」
沈藹莉教授的團隊在漁護署的魚類健康檢查計劃中與該署 緊密合作。當漁護署轉介需要魚類疾病診治服務個案時, 她的團隊就會推介漁護署為新魚苗專設的免費篩查計劃; 另一方面,團隊要靠漁護署篩查世界動物衞生組織所列的 病毒病原體。從長遠角度看,雙方的合作有助促進本地魚 類養殖產量。
這些服務亦為修讀城大獸醫學學士課程的學生提供很多機 會,擴闊未來就業前景。
沈藹莉教授說:「我們的學生將有機會隨魚類獸醫到本地 漁場實習,協助調查魚類疾病及管理魚類健康。一項有關 魚類藥物的臨床實習項目訂於2023年開辦,於獸醫學學 士課程的畢業年進行。」


城大會與政府緊密合作,致力促進魚類健康和更適合持續 發展的魚類養殖環境。

When told they have cancer and only have a year or so to live, people usually feel distressed or hopeless. But what happens when dogs get cancer?
Dr. Antonio Giulian, specialist in oncology at CityU Veterinary Medical Centre (CityU VMC), says, “Dogs are as cheerful as usual. They might be aggressive the first time we meet, but they get friendlier each time they turn up at the clinic.”

Dr. Antonio usually sees patients in the morning and buries his head into medical equipment such as CT scanners, ultrasound machines and echocardiography equipment in the afternoons. But as an oncology veterinarian specializing in tumours and cancer among dogs and cats, he estimates that half his working time is spent simply talking to pet owners.
He recalled, “Mostly I need to handle the owners’ emotions. They are saddened by their pets’ suffering, and are anxious about saying goodbye to their beloved companion. Some of them can be quite emotional. Their feelings are understandable, and my job is to help them make their decisions carefully.” Dealing with such grim situations every day is surely not easy so why did he choose oncology in the first place?
With a smile, he answered, “It is only the people who feel grim. Animals with cancer aren’t sad, they are as happy and cheerful as ever.”
More importantly, not all cancers are terminal. Dr. Antonio said, "Being diagnosed with cancer isn't necessarily a death sentence. How aggressive the cancer is depends on its type and stage. Some
cancers can kill an animal with time, but sometimes an animal can live with the disease."
Another reason he chose to be an oncology veterinarian: this is an ever-changing and very challenging discipline.
“The same tumour may lead to different outcomes on different animals, different body parts or at different stages. Veterinary Oncologist deal with new cases every day. I have worked in this area for over a decade, but I still constantly encounter new things. My work never bores me.”
The ever-changing tumours also mean that most treatments are optional. Each option has pros and cons, which veterinarians have to analyze and explain with a lot of patience, so pet owners can make the best decision. Empathy is also an important character trait for veterinarians: they need to be able to build trust with the owners, and support them during their pets’ last path in life.
Dr. Antonio understands these owners’ sadness as he had also once lost a beloved pet. While he was living in the UK, his 16-year-old bulldog lost her sight and mobility. Dr. Antonio had to carry her around every day. He was initially reluctant to consider euthanasia, despite his friends’ opinion. Then he finally pulled himself together and asked himself an honest question: “She couldn’t see or walk, and was simply deprived of any enjoyment in life. Was I prolonging her life for her, or me?”
This experience was important in Dr. Antonio’s development as a vet, allowing him to offer professional medical counsel to pet owners while empathizing with them as a fellow pet lover who has experienced a similar loss. For Dr. Antonio, quality of life is the most important in a pet’s final days. “Lifespan means nothing to animals. Even if they were to die tomorrow, they would still be happy as long as they can eat and walk. Without these pleasures they would be deprived of their quality of life. We will all die one day. Instead of giving animals a long life, let’s give them a good one.
After graduating from the University of Messina in Italy and completing a master’s degree in Small
當一個人患上癌症,只餘下一年生命時,可能心急如焚, 可能萬念俱灰,但如果狗患上癌症呢?城大動物醫療中心 腫瘤科專科獸醫Antonio Giuliano答:「牠們依然快快樂 樂,第一次見我可能惡形惡相,但以後覆診會愈來愈熱情, 每次見我都比之前更開朗。」
Antonio獸醫常在早上診症,下午處理磁力共振、超聲波、 心電圖等醫療程序。這位腫瘤科獸醫專門治療小貓小狗的 腫瘤和癌症,其中一半時間全用來跟寵物主人聊天。
他說:「大部分是處理寵物主人的情緒,他們為了寵物要 受苦而難過,又為快要跟寵物分離很傷心,有些主人會變 得很激動。我很明白這種心情,要勸他們不要倉促做決 定。」每天面對如此沉重的情境,想起來也不易過,他當
初何以選擇投身腫瘤科呢?
Antonio獸醫微笑答:「所謂沉重只是對人而言,患癌的 動物依然樂天開朗,根本不知道主人愁甚麼。」
更重要的是,不是所有癌症都是不治之症,Antonio獸醫 強調:「患癌不代表甚麼,這個疾病是否兇猛,視乎癌症 的種類和階段,有些癌症會慢慢奪去動物的生命,但有時 動物可以跟癌症並存。
他當腫瘤科獸醫的另一個原因,是腫瘤科病例千變萬化, 極有挑戰性。
「同一個腫瘤,對不同的動物、在不同的身體部位,於不 同的階段,可以有截然不同的結果。腫瘤科獸醫面對的病
Animal Oncology at the University of Pisa, Dr. Antonio further studied cancer therapeutic and small animal oncology in the UK. After completing an oncology residency and working as an oncology clinician at the Queen’s Veterinary School Hospital at the University of Cambridge, he joined City VMC in 2019.
Dr. Antonio appreciates Hong Kong people’s loyalty to their pets and their willingness to do everything they can to cure a sick pet. They are also very grateful to their vets: “It may be because veterinary oncologist are not that common in Hong Kong. Compared to Europe where people are more used to seeing their pets recover from cancer, Hong Kong people never hesitate to show you how thankful they are to see their pets get better. This always warms my heart.”
例幾乎天天新款,即使我當了獸醫十幾年,仍經常遇上意 想不到的事,我從不嫌自己的工作沉悶。」

腫瘤病例千變萬化,治療方法五花八門,因此獸醫更需要 無比的耐性,跟寵物主人仔細分析各種方法的利弊,讓他 們作出最明智的決定。獸醫也需要同理心,跟寵物主人建 立互信,協助他們陪伴寵物走完最後一段路。
其實Antonio獸醫自己也是過來人,因此很明白這些寵物 主人的感受。他在英國生活時,陪伴他十六年的老虎狗老 來雙眼失明,行動不便,常要抱着牠出出入入。朋友勸他 讓小狗安樂死,他總是依依不捨,等他冷靜下來思考:「牠 看不見、走不動,已經難很享受生活,我勉強要牠留在世 上,到底是為了牠好,還是為了我自己?」
這段經歷對他十分重要,他可以用獸醫角度跟寵物主人作 科學分析,也能用過來人身分好言開解。Antonio獸醫認 為寵物在生命最後一程路上,最重要的是生活質素,「動 物對壽命沒有概念,即使明天要死了,只要可以吃、可以 走,便會活得很快樂,如果連那些享樂都失去,就難再有 生活質素了。死亡始終會來,與其要動物活得最長久,不 如讓牠們活得最安樂。」
Antonio獸醫在意大利梅西納大學獸醫科畢業後,先在意 大利比薩大學修讀小動物腫瘤科碩士,再在英國進修癌症 治療及小動物內科。他曾在英國劍橋大學轄下的皇后獸醫 學院醫院完成腫瘤科獸醫訓練,再在該醫院擔任腫瘤科獸 醫,於2019年來港加入城大動物醫療中心。
他讚賞香港人對寵物不離不棄,會用盡方法醫好生病的毛 孩。他說香港寵物主人另一個特點,是經常流露出對獸醫 的感激之情:「也許香港治療腫瘤或癌症的獸醫不多,當 一隻患癌寵物身體好轉時,歐洲人覺得是理所當然的事, 香港人會覺得十分感恩,不斷向你道謝,我作為獸醫會覺 得很感動。」
When the City University of Hong Kong first established the Department of Biomedical Sciences, some were doubtful about its graduates’ career prospects. It wasn’t until the first cohort of the Bachelor of Sciences in Biomedical Sciences (BMS) students graduated in 2017, many of them becoming well-paid medical laboratory technologists at public hospitals, that people realized just how promising the future was for these biomedical sciences graduates.
Medical laboratory technologists work at public and private hospitals as well as diagnostic laboratories. They perform medical laboratory tests on specimens of body tissues, fluids, blood and urine to help doctors make diagnoses and evaluate treatment.

Sandy Lo Ka-ki, 2017 BMS graduate and assistant medical laboratory technologist at Pamela Youde Nethersole Eastern Hospital, said her job is like a detective of diseases who works behind-the-scenes to help doctors understand diseases.

She recalled the time when she had to perform a Thalassemia test for a pregnant woman. She was confused when the blood test indicated possible HbH disease despite a normal blood smear. She and her colleagues kept digging deeper, finally confirming Thalassemia in another blood smear, helping the doctor to make an accurate diagnosis. She said, “Had we given up, the doctor would have made a wrong diagnosis. Our tests helped the patient to reconsider whether she would continue the pregnancy in view of the possible complications.”
Practical programme equips graduates with working skills
Sandy has always been interested in public health and medical care but being in the front line was not her cup of tea. “I prefer to work behind the scenes. Two years into the job, I have come to realize that many tasks that seem insignificant have, in fact, a huge implication on patients. A speedy, accurate test result is essential in helping doctors make correct diagnoses and decide on the best course of treatment. Our role is no less important than that of the medical staff at the forefront. It is very satisfying.”
Another alumnus Winnie Wu So-Yat said that the comprehensive BMS programme, consisting of
theoretical and practical issues and covering the 4 major areas of clinical biochemistry, haematology and serology, histopathology and cytopathy, as well as medical microbiology, prepared her well for her role as assistant medical laboratory technologist at the North Lantau Hospital. “The curriculum and laboratory classes were designed to accurately reflect real-life situations, and I was able to hit the ground running when I started my job,” she said.
Not only does the Department of Biomedical Sciences boast a faculty of internationally renowned scholars, it also frequently invites industry veterans, including former Hospital Authority senior technicians, to give guest lectures. BMS students are able to intern at local or overseas hospitals. In the summer before her graduation, Winnie took a 2-month internship at Taipei Veterans General Hospital in Taiwan, where she had the experience of dressing up in full medical protective equipment to work in the tuberculosis laboratory. She said, “The internship allowed me to apply all the theories I had learned in the classroom. Not only did this help me a lot on my Final Year Project, it also made me much more confident in starting my career.”
With an aging population in Hong Kong, there is a bigger demand for healthcare workers including medical laboratory technologists. New graduates can expect an attractive monthly salary of nearly HK$30,000. Winnie recognizes the stress of being a medical laboratory technologist, given the role’s importance in supporting doctors’ diagnoses. “But if you enjoy working with statistics and can work with
precision, you’ll love this job, as I do,” she said with a smile.
Curious and knowledge-thirsty people would also love this discipline. 2017 graduate Anthony Pang Lok-Kan is currently pursuing his master’s degree in biomedical sciences while working as an assistant medical laboratory technologist at Hong Kong Children’s Hospital. His goal is to follow a career progression from assistant medical laboratory technologist, to medical laboratory technologist to senior medical laboratory technologist.

He fondly compares his school days to being surrounded by a vast ocean of knowledge. He enjoyed learning, reading reference books in his spare time and would even reread his notes as soon as stepped out of the lab. For his Final Year Project, he investigated the antibacterial effect of a Chinese herb Euphorbia hirta. He performed microbiology tests while his teammate gathered the chemical data, and they completed the project under the guidance of their professor.
Anthony recalls, “All of our professors were friendly and responsive. They would spend a lot of time preparing class notes and illustrations to make difficult knowledge understandable for us. Every lesson was amazing. I still keep in touch with those professors and I am happy to go back to school and share my experiences with current students.”
According to the Hospital Authority’s statistics, there were 3,273 medical laboratory technologists as of 1 May 2016. They have a promising future with clear career progression prospects.
Assistant medical laboratory technologists
Income: $27,690 to $47,007
Medical laboratory technologists
Income: $49,158 to $70,981
Senior medical laboratory technologists
Income: $79,552 to $98,235
Upon graduation, students can work in various areas, such as:
• Diagnostics sector in medical and health industries
Medical and Health Services
• Medical devices in the health industries
• Pharmaceutical and laboratory instrumentation industries
• Professors/ lectures in universities
當香港城市大學成立生物醫學系時,有些人擔心這學科的 事業出路,直至第一屆生物醫學學士課程學生於2017年 畢業,許多在公營醫院任職待遇優厚的醫務化驗師,大家 才曉得這個學系引領去的是另一條康莊大道。
Education and Research
• Principle investigators in universities and non-profit research institutes
• Scientists/ researchers in pharmaceutical and biotech R&D industries


• Product marketing and sales
Management and Consultant
• Consultancy services
• Laboratory management
• Clinical trials management
• Environmental Protection Department
醫務化驗師主要於公私營醫院及私營化驗室工作,從人體 組織、分泌物、血液、尿液等取樣本化驗,協助醫生診斷 疾病、評估治療成效等。在東區尤德夫人那打素醫院任職 副醫務化驗師的盧嘉琪第一屆生物醫學系畢業生形容,化 驗師的工作猶如一位病理偵探,在醫生背後為疾病抽絲剝 繭。
Government
• Food and Environmental Hygiene Department
• Agriculture, Fisheries and Conservation Department
• Patent law firm
她憶述曾經為一位孕婦驗地中海貧血,明明血液指數偏向 中型海洋性貧血,但血液抹片卻屬正常,她跟同事鍥而不 捨追查,終於在一個血液抹片確實她患有地中海貧血,協 助醫生做正確的診斷。她說:「如果當日我們半途而廢, 令醫生做錯診斷,那位孕婦可能誕下不健全的嬰兒,但我 們的化驗讓她重新思考是否生育。」
Others
• Public health
• Journalism
嘉琪回想當初選擇生物醫學科,因為對公共衛生及醫療有 興趣,卻覺得自己不適合在前線衝鋒陷陣,「 我喜歡在後 台支援,默默耕耘又幫到人,我至今做了兩年,才明白很 多平平無奇的工作原來對病人有舉足輕重的影響,因為準 確快速的化驗對醫生診斷、選擇治療方法十分關鍵,我們 的貢獻跟前線醫護人員一樣,令我很有滿足感。」
另一位校友鄔素逸說,生物醫學系課程包涵理論和實踐, 全面涵蓋醫療化驗科學的四大範疇:臨牀生化學、血液學 及血清學、組織病理學及細胞病和醫療微生物學,讓她在 北大嶼山醫院上任副醫務化驗師即能應付自如:「我們讀 書時常在實驗室上課,課程內容和工作環境貼近現實情 況,因此一入職便能上手。」
城大生物醫學系的教授都是國際知名的學者,又會邀請業 界的資深人士包括前醫管局資深技術員授課,還會安排學 生在本地及海外的醫院實習。素逸在畢業前一年的暑假在 臺灣臺北榮民總醫院實習兩個月,試過全副裝備進入俗稱 肺癆的結核科實驗室,她說:「那次實習將我們學過的理 論很完整地應用一次,除了對我做學期年終報告十分有 用,也令我更有信心投入職場。」
隨着香港人口老化,不同崗位的醫護人員愈來愈緊絀,因 此醫務化驗師這個行業大有需求,大學畢業生剛入職便有 接近30,000元的月薪。素逸說醫務化驗師每項工作對醫生 診斷影響深遠,因此壓力也不小,她笑說:「但若你喜歡 做數據統計,做事很嚴謹精確,你會很喜歡這個行業,而 我就是這樣的人。」
這個學科亦很適合求知慾大、愛進修的人。同樣於2017 年畢業的彭樂勤在香港兒童醫院任職副醫務化驗師,同時 修讀生物醫學碩士課程,希望將來在這個行業逐步攀升, 由副醫務化驗師、醫務化驗師晉升到高級醫務化驗師。
他很享受當年沉淫在知識的大海裏,他愛在課餘看參考 書,踏出實驗室便翻閱筆記。他的學期年終報告研究中藥 成分飛揚草在微生物學的抗菌作用,他的同組同學專注化 學數據,他則專注生物實驗,在教授的循循善誘下完成報 告。
樂勤回憶說:「我最印象深刻的是,每位教授都很友善, 有問必答,他們會花很多心思預備筆記和圖表,將深奧的 學問由淺入深教授我們,當年的課堂真的很精彩。我跟這 些教授仍然保持聯絡,畢業後仍會回校跟現屆學生分享。」

畢業生可投身多種職業,包括:
• 醫療健康機構診斷部門
• 健康醫療設備
• 製藥及實驗室儀器
根據醫管局的數字,截至2016年5月1日, 本港有逾3,273 名註冊醫務化驗師。醫務化驗師可以層層晉升,前景美好。

副醫務化驗師 薪酬 27,690至47,007元
醫務化驗師
薪酬 49,158至70,981元

高級醫務化驗師 薪酬 79,552至98,235元
• 大學教授或講師
• 大學及非牟利研究機構
主要研究員
• 製藥及生物技術研究機
構的科學家或研究員
• 產品營銷與銷售
• 顧問服務
• 實驗室管理
• 臨床試驗管理
• 環境保護署
• 食物環境衛生署
• 漁農自然護理署
• 專利律師事務所
• 公共衛生
• 傳媒
Heart disease has become the leading cause of death worldwide, with the majority of fatalities caused by coronary artery disease and correlating heart failure. Dr Kiwon Ban, JCC’s Assistant Professor of Department of Biomedical Sciences, always feels a pang of sympathy for late-stage heart-failure patients.


“They have very few options. The possibility of a heart transplant is dependent on the availability of suitable hearts donated by others, but since these are limited many patients die waiting. Heart devices are limited by battery life: battery replacement requires surgery, exposing these patients – mostly the elderly in their 60s or 70s, to greater risks,” he explained.
This is why Dr Ban has been dedicated to developing novel therapeutic applications for stem cell-based cardiac regeneration.

His recent discovery of “in vivo priming”, which can prime human mesenchymal stem cells (hMSCs) in intact hearts in vivo, has been published in the internationally acclaimed journal Science Advances. The current stem cell-based therapeutic applications have their own limitations. For example, hMSCs only achieves approximately 3 to 4% improvement in the left ventricular ejection fraction (LVEF), and priming application only provides a short-term benefit. The protective effects conferred by ischemic preconditioning (IPC), which begins within minutes
after the IPC stimulus, was maintained for only 4 to 6 hours.
Dr Ban’s novel application, however, keeps the priming effect of hMSCs more consistent and effective. The primed human bone marrow (BMMSCs) achieved a higher survival rate compared with unprimed BM-MSCs in the patches attached to the myocardial infarction (MI)-induced hearts, which led to a significant improvement in cardiac function and an enhancement of vessel formation after MI.
潘博士研究範圍
• 人類多能幹細胞心血管再生
• 人類多能幹細胞產生結構和功能成熟的心肌細胞
• 制訂人類心肌細胞移植的最佳策略
• 了解人類心臟病的病理生理學
Dr Ban’s research Interests
• Cardiovascular regeneration with human pluripotent stem cells

• Generation of structurally and functionally mature cardiomyocytes derived from human pluripotent stem cells
• Development of optimal strategies for transplanting human cardiomyocytes for cardiac regeneration
• Understanding the pathophysiology of human heart disease
Dr Ban still remembers the excitement he felt when he completed his research, which took two years and involved many experiments and a lot of collaboration between South Korea and CityU. “Not only does this discovery help late-stage heart failure patients live longer, the results of this study also carry significant implications for future stem cell therapy in cardiac repair. It’s fantastic!” he said with a big smile.
To Dr Ban, a veterinary school is not only for curing animals; it can also enhance human health. With the support of JCC’s experts, he conducted his research on small animals, but the research results will ultimately benefit mankind.
“A biomedical scientist may have many new ideas, but he needs the support of veterinary experts in order to turn them into novel therapeutic applications. Together we aim to create a better future for human society.”
Therefore, after obtaining his PhD degree in Cardiovascular physiology at the University of Toronto, Canada, as well as Post-doc and Instructor degrees in Cardiac stem cell biology at Emory University, USA, he joined JCC, the only veterinary college in Hong Kong, to pursue his biomedical science research.
心臟病奪去世界各地很多生命,很多人因為冠狀動脈疾病 或心力衰竭而死,因此,賽馬會動物醫學及生命科學院生 物醫學家潘基沅博士對心臟病末期病人深感同情。
他解釋:「他們的選擇很少,心臟移植要依賴其他人捐贈 適當心贜,但數量有限,很多病人等到去世。心臟起搏器 又有電池壽命限制,病人要做手術更換電池,他們大部分 是60、70歲的長者,這些手術有一定風險。」
因此,他一直致力研發基於幹細胞的心臟再生新型治療。
他最近研發的體內啟動可在病人體內實現間質幹細胞啟 動,其論文最近於國際著名期刊《科學進展》發表。
目前基於幹細胞的治療各有缺點,例如間質幹細胞在左心 室射向分數(LVEF)只達到3%至4%的改善,而啟動治 療的效果極短。缺血啟動後幾分鐘開始有保護作用,但僅 維持4至6小時。
相反,潘博士的新治療法可令間質幹細胞的啟動效果更持 續有效,將人骨髓藉附貼於心肌梗塞心臟的貼片啟動,比 未啟動的人骨髓存活率更高,令心臟功能顯著改善,改善 心肌梗塞後的血管形成。
潘博士仍記得這個研究經歷兩年,在南韓和城大之間進行 多次實驗和合作,他在完成一刻興奮無比,他笑着回憶: 「這個研究不單可以延長末期心臟病人的壽命,研究結果 亦對修復心臟的幹細胞治療意義深遠,十分美妙!」
對潘博士而言,獸醫學院不單治療動物,也可促進人類健 康。他在小動物身上進行研究,過程中得到賽馬會動物醫 學及生命科學院一眾專家支援,而研究結果最終可以造福 人類。
他說:「一個生物醫學家即使有很多創新想法,也要一班 動物專家配合,才能將自己的概念化成治療方法,最終我 們攜手造福人類社會。」
因此,他獲得加拿大多倫多大學心血管生理學博士學位、 美國埃默里大學心臟幹細胞生物學後博士及講師學位後, 加入香港唯一的獸醫學院——賽馬會動物醫學及生命科學 院,繼續從事他的生物醫學科學研究。

Fighting cancer is a long battle. From the discovery and diagnosis of the tumour to surgery, to the lengthy treatment that follows – the journey is draining enough as it is. For patients with resistance to certain drugs, the ordeal is made even more taxing by the necessary search for alternative treatment methods, as well as further tests and surgeries.
A ground-breaking new blood test, however, could offer new ways to help these cancer patients.

A biomedical research team at Jockey Club College of Veterinary Medicine and Life Sciences has developed a new technology that could detect cancer cells in the circulation system, through a blood test using just 4ml of the patient’s blood. The “cell manipulation and test platform based on microfluidic chip” technology identifies tumour cells circulating in the blood, which means that patients can expect an accurate cancer diagnosis without biopsy surgery.
The research team behind this technology is led by Professor Michael Yang Mengsu, Acting Dean of the Jockey Club College of Veterinary Medicine and Life Sciences and Yeung Kin Man Chair Professor at Biomedical Sciences at CityU. Key members of the team include Dr Henry Zou Heng, Dr Edwin Yu Waikin and Dr Xu Tao, all Senior Research Associates in the Department of Biomedical Sciences at CityU.
“Although existing blood tests can identify cancer markers, we had a loftier goal – to be able to confirm the existence of cancer cells directly through bloodwork. It was a very difficult process. Our breakthrough was developing not only the world’s fastest, but a highly accurate detection of circulating
tumour cells through identifying the physical and biological characteristics of tumour cells using a microfluidic chip,” said Dr Yu.

Currently, cancers are diagnosed through conventional methods like medical imaging, tissue biopsy, or blood protein testing to identify tumour markers. But these cancer detection methods only have limited sensitivity and specificity. With JCC’s new technology, the accuracy and specificity of the tests can reach over 90%.


This new development also contributes to more effective monitoring of patients’ condition. Using this technology, doctors can analyse the gene mutations and protein expression of the cancer cells, yielding results more accurate than gathered from biopsies. This allows doctors to confidently determine whether targeted therapy or immunotherapy is an appropriate treatment for the cancer patient. The test can also be used to detect any drug resistance, helping doctors decide if new medication or treatment is required.
“If we can screen and monitor the disease at an early stage, we can offer patients more timely treatment and the best hope for recovery. This is what this new technology allows us to do. Not only that, it will let us review the effectiveness of the treatment regularly and make adjustments as appropriate.” Said Dr Zou.
抗癌是一場漫長的戰役。當一個人發現自己長了腫瘤,首 先要做手術抽取腫瘤組織化驗,確定患癌後便開始漫長的 治療過程。若他對某種藥物有抗藥性,便要嘗試其他治療 方法,可能又要再做手術,這些折騰令癌症病人更為辛苦。 賽馬會動物醫學及生命科學院的生物醫學研究團隊,最近 研發了一項新技術,為這些癌症病人帶來新曙光。
團隊研發出「微流控芯片上的細胞操控與檢測技術平台」 技術,只要透過病人4毫升的血液就能在血液循環系統檢 測出罕有的腫瘤細胞,而且全程以抽血方式進行,意味着 病人毋須為化驗癌細胞而做活檢手術。
研究團隊由城大賽馬會動物醫學及生命科學院署理院長兼 楊建文講座教授(生物醫學)楊夢甦教授領導,主要成員 包括城大生物醫學系高級副研究員鄒恒博士、余瑋健博士 及徐濤博士。
余博士說︰「雖然現時可以用血液檢驗癌症指標,但我們 要做的是直接從血液中檢測出癌細胞的存在,這個技術十 分困難,我們的突破就是利用微流控技術,以細胞的物理 化和生物特性作識別,檢測循環腫瘤細胞的速度是全球最 快的,而且準確度極高。」
現時確定癌症的常見方法包括影像檢測、腫瘤組織化驗, 以及測試血液中腫瘤分泌出來的蛋白標記物,但這些技術 的靈敏度和特異性不高。賽馬會動物醫學及生命科學院的 研發成果,將檢查結果的特異性及靈敏度提升至90%以 上。
這項發明的另一貢獻是監控癌症病人的病情。醫生可透過 腫瘤細胞技術,分析病人癌細胞的基因突變和表面的蛋白 訊息,確定他是否適用標靶治療或免疫治療藥物,結果比 抽取組織化驗更為準確。此技術亦可測試病人是否對藥物 有抗藥性,讓醫生確定是否要換藥或改治療方案。
鄒博士表示︰「我們希望病人透過早期的篩查及監控病 情,能夠及早作出治療,以免錯過了最佳的診治時間。病 人亦可透過定期血液檢查檢討治療效果,因應病情調節治 療方案。」

 Olivier Sparagano
Olivier Sparagano
Veterinarians have a key role in preventing zoonotic diseases between animals and humans and to ensure the best welfare and food production for animals to ensure the best food quality and food safety for humans. As seen in the coronavirus epidemics the health status of animals can greatly impact on the health of humans.
As the Course Leader for Food Safety and Regulations (VM3003) within our BVM program it is important for our veterinary students to see how in future they could be involved in the Food industry as food and feed inspectors, animal welfare experts working for governmental agencies or the food industry. However, universities cannot recreate such facilities on campus and need to develop key partnerships with such industries.
Photos with permission from the Regal Kowloon Hotel 照片獲富豪九龍酒店授權Therefore, to expose our students to the state-ofart in food safety and regulations we were delighted to partner with Regal Kowloon Hotel, which on two occasions showed our students during this academic year their highly performing facilities. Mr Marco Ho (Assistant Director for Food and Beverage), Mr Tommy Ng (Group Hygiene) and Mr Creash Wong (General Manager at Metropolitan Food and Beverage Limited) from the Regal Kowloon Hotel showed Professor Sparagano and his students and Dr Howard Wong, all from City University their Metropolitan Central Kitchen and the Regal Kowloon Hotel in Kowloon, Hong Kong SAR, including informative lectures about their business and strategies.
Students, while visiting such facilities, have learned about food labeling, food ordering, food preparation, cooking and delivery to customers including the Hazards Analysis and Critical Control Points (HACCPs) rules and related legislation such facilities need to abide to. They also learned about hygiene good practice and keeping food tasty and safe.
Such University-Industry partnership is key to bring the best expertise to our students and allow them to be better prepared for their future career.
We are grateful to the Regal Kowloon Hotel and related subsidiaries for such fantastic opportunities for our students.
Olivier Sparagano教授
賽馬會動物醫學及生命科學院傳染病與公共衛生學系寄生蟲學教授
JCC was also honoured to have Mr. Tam Chi Wai, former Senior Superintendent with the Centre for Food Safety, assisting Professor Sparagano in providing a unique local perspective of the challenges faced by governments in ensuring food safety for the population.

獸醫致力阻擋人畜共患症,確保動物福利和動物食品的質 素,從而保障人類的食物安全,最近的新冠肺炎足以證明 動物健康對人類健康影響極大。
我擔任獸醫學學士課程科目「食物安全及規格」 (VM3003)的科目主任,必須讓我們的獸醫科學生展望 未來,知道自己將來可以任職食品行業的食物及飼料偵查 員,或政府部門及食品行業的動物福利專家。然而,大學 校園無法模擬這些情境,因此我們要跟相關行業建立合作 關係。
因此,我們慶幸跟富豪九龍酒店合作,讓學生認識先進的 食物安全及規格。富豪九龍酒店在本學年兩次讓我們的學 生參觀一流的業界設施,酒店的餐飲助理總監及其他代表 帶領王啟熙獸醫、Olivier Sparagano教授及他的學生參觀 大都薈中央廚房及富豪九龍酒店,並安排一個有關酒店業 務策略的講座。
獸醫課程學生透過參觀這些設施了解食物標籤、食品訂 購,以及食物從準備、烹調到送交顧客的程序,包括業界 須遵守的「危害分析和關鍵控制點」規則及相關法律,學 生因此明白如何保持設施衛生,令食物更美味可靠。
大學與各行業的夥伴關係十分重要,不單讓學生了解行內 專業運作,也為未來事業作更好準備。
我們感謝富豪九龍酒店及附屬公司為我們的學生帶來這些 美好體驗。
JCC還很榮幸邀請到前食物安全中心高級總監譚志偉先生 協助Sparagano教授,就政府在確保市民食物安全方面面 臨的挑戰提供獨特的本地視野。
Professor Olivier Sparagano Professor of Veterinary Parasitology in the Department of Infectious Diseases and Public Health in the Jockey Club College of Veterinary Medicine and Life Science.CityU VDL continues to make an impact on disease diagnosis for animals in Hong Kong. With a comprehensive range of the latest technology available in the laboratory at City University, laboratory staff are able to swiftly and accurately provide diagnoses on animal disease to their owners. Testing of various samples from pets, horses, pigs, chickens and aquatic species proceeds six days per week in the laboratory. Having on site specialists, highly qualified technologists, scientists, and the latest diagnostic equipment means accurate results can rapidly be returned to submitting veterinarians, so animals can be treated or disease prevented.
A number of projects are being undertaken in the course of routine work and important diseases have been identified and investigated.

Registered specialist pathologist Dr Janine Sandy is recording and analyzing the types of mammary tumours occurring in cats and dogs in Hong Kong. She has found the average age of tumour development in dogs is around 10 years, while in cats, the average age of tumour development is slightly older at around 13 years of age. This valuable study is ongoing and should provide information on the types of mammary tumours in both dogs and cats and if there are any interventions owners could make with their pets to prevent tumour occurrence or manage disease successfully.
A number of new organisms affecting pets in Hong Kong have been identified. One is infection with Leptospira interrogans , causing leptospirosis. Leptospirosis infection in dogs is usually diagnosed by Hong Kong veterinarians during the wet summer period.
Work over the past two years at City U VDL has revealed a new serogroup of leptospirosis affecting dogs in Hong Kong. Serological testing found the organism was part of the Leptospira interrogans serogroup Hebdomadis . Initial studies in the laboratory worked on developing a molecular test to identify the bacteria causing disease. Once this work was completed, additional investigations were undertaken to further define the genetic nature of the infecting bacteria. Leptospira DNA from the urine of infected dogs was extracted in the molecular laboratory (Figure 1 and 2).
Once the DNA is extracted, the extract can be sent to specialized laboratories in Hong Kong for genotyping and genetic sequence analysis. This work found five different leptospira profiles within local infected dogs throughout the Hong Kong area. Two of the profiles were new and had not been identified in dogs before. Further diagnostic investigations will be undertaken in the wet season of 2020, while the results have been shared with the JCCVMLS for possible future research studies.
Other new organisms found include various types of fungi, parasites and protozoa infecting dogs, rabbits, and cats. Investigations are ongoing into many of these diseases.
To improve the efficiency and accuracy of antibiotic sensitivity testing, a specialized computer controlled microbiology plate reading device was installed in the microbiology laboratory. This technology is being utilized to support critical research projects investigating the incidence of antibiotic resistant bacteria in animals and animal products in Hong Kong. Bacteria are first cultured on agar plates (Figure 3) before identification by mass assisted laser desorption ionization time of flight (MALDI-TOF ) (figure 4).
Antibiotic coated discs can then be applied to pure colonies of the bacterial isolate and assessed for efficacy by measuring the zone of inhibited bacterial growth.

These studies will help medical and veterinary professionals in Hong Kong strategise and rationalize the use of antibiotics in Hong Kong.
agentsneedto beseparatedfrombloodorurine priortoidentification. Asubsample ispipettedfromtheoriginalsample aftercentriguation.

圖一:鑑定前要先將感染劑血液或尿液 以離心分離,再在原樣本中抽取子樣本。
CityU VDL has established an important role in the investigation of animal diseases in Hong Kong, showing the value of local expertise and technology in the recognition of new diseases and control of existing disease.
城大動物醫療中心繼續為香港的動物診斷疾病。位於城大 校園的實驗室擁有全方位的先進技術,令實驗室職員可以 為寵物主人提供迅速準確的動物疾病診斷。實驗室化驗來 自寵物、馬匹、豬、雞及水產物種的樣本,一星期運作六 天,全賴得一眾駐場的專家、專業的技術員、科學家及先 進診斷儀器,獸醫可以快速獲得化驗結果,令動物得到治 療及預防疾病。
實驗室在日常工作之上亦展開新項目,我們進行偵查,發 現了重要疾病。
註冊病理學家Janine Sandy獸醫正記錄及分析香港貓狗 的乳腺腫瘤,發現狗隻平均在10歲左右長出腫瘤,貓則 年長一點,平均在13歲左右出現腫瘤。這項重要研究仍 在進行,令人更了解貓狗的乳腺腫瘤,若主人及早行動, 可以預防寵物患上腫瘤,或得到適當治療。
香港出現一種會傳染寵物的新生物,是引起鉤端螺旋體病 的致病性鉤端螺旋體種(Leptospira interrogans),香 港獸醫常在潮濕的夏季,發現狗隻染上這個疾病。
經過兩年的努力,城大動物醫療中心發現一種會感染 香港狗隻的鉤端螺旋體新血清群,血清測試證明這 種生物體屬於致病性鉤端螺旋體種血清群「七日熱」 (Hebdomadis)。實驗室首先要研發一項分子測試,以
Figure
areusedto multiplybacteriafromsamplessothey can be identified 圖三:在瓊脂板上培植細菌,再作鑑定。
激光檢測質譜儀(MALDI-TOF)鑑定。
確定引致疾病的細菌,當這項工作完成後,下一步偵查工作是 確定感染細菌的遺傳性質。分子實驗室抽取感染狗隻尿中的鉤 端螺旋體去氧核糖核酸。(圖一及圖二)
職員把抽取出來的去氧核糖核酸送到香港的專門實驗室,進行 基因分型和遺傳序列分析,並發現香港多區狗隻感染五種鉤 端螺旋體,其中兩種是從未在狗隻身上發現的新品種,將於 2020年雨季進行診斷研究。這些化驗結果已呈交賽馬會動物 醫學及生命科學院,以考慮作進一步研究。
其他新發現的生物體包括多種真菌、寄生蟲及原生動物,可以 感染狗、兔和貓,實驗室職員正在研究這些疾病。
微生物實驗室安裝了一台以專用電腦控制的微生物板閱讀器, 以提高抗生素敏感度測試的效率和準確度,這項技術有助研 究香港動物及動物產品中的抗生素抗藥性細菌。實驗室職員 會先在瓊脂板上培植細菌(圖三),再以快速激光檢測質譜儀 (MALDI-TOP )(圖四)鑑定。
然後,將塗有抗生素的碟片放在細菌分離的純菌落,通過量度 抑制細菌生長區域來評估功效。
這些研究有助香港醫學及獸醫學專業想出辦法,令香港人更有 效使用抗生素。
城大動物醫療中心對偵查香港動物疾病舉足輕重,彰顯出本地 專家及技術也對確認新興疾病及控制現有疾病作出重大貢獻。
Figure1:Infectious Figure2:DNAextractionisundertaken byaroboticextractiondevice 圖二:以機器人抽取機抽取去氧核糖核酸。 3:Agarplates

As Hong Kong’s first veterinary medicine school, the Jockey Club College of Veterinary Medicine and Life Sciences (JCC) strives to form a worldclass faculty by bringing together international scholars from different specializations and backgrounds. The aim is to nurture a crop of talented veterinary medicine professionals, in Hong Kong and the Asia Pacific region, that can tackle alarming public health problems such as zoonotic diseases and anti-microbial resistance.
JCC is pleased to welcome two renowned feline veterinarians to its faculty this year: Professor Vanessa Barrs, who is taking up the post of Chair Professor of Companion Animal Health and Disease, and Professor Julia Beatty, joining as Chair Professor of Veterinary Medicine and Infectious Diseases. Both professors have been teaching at the University of Sydney, Australia for 15 years.
The two professors have worked as a team for years and have decided to take up the positions at JCC together. They explained, “JCC plays an important role in the Asia-Pacific region, and has successfully gathered veterinarians, researchers and scientists of various nationalities, each with their own expertise and insights. It is a pleasure to be part of such a team to advance
the institution’s excellence in veterinary medicine. It is challenging, yet very meaningful.”
Besides teaching experience spanning 15 years, the two professors have each also accumulated individual research achievements. Specializing her research in animal infectious diseases caused by fungi and viruses for years, Professor Barrs discovered an emerging agent of invasive aspergillosis of animals and humans in 2013, Aspergillus felis. Her research has shed light on clinical, diagnostic and therapeutic aspects of disease caused by this pathogen in cats. “A good veterinarian does not stop at removing the symptoms of a disease, but continues to explore the pathologies behind the disease so that it can be prevented and cured. This is the spirit of science: curiosity and a thirst for truth and knowledge,” she said.
Professor Barrs will focus on the College’s curriculum development, ensuring it is in line with international standards. “Today, veterinary medicine is no longer a discipline on its own but a holistic discipline that promotes the integration of One Health in the whole world. With problems such as anti-microbial resistance and zoonotic diseases like Dengue Fever and Avian Flu posing major threats to human health, veterinarians, doctors as well as experts in other disciplines have to join hands in finding solutions. The College needs a curriculum that keeps up with current development and is focused on the future of humankind,” she said.
Professor Barrs also pointed out that important stakeholders of One Health span from the local poultry industry, be it pig farms, fish farms or chicken farms, to animal shelters of all scales. “Our experts from different disciplines will provide strong back-up to the industry. I will lead the college in cooperating with them to improve their management and promote animal health. It is important to educate the industry that healthier animals mean less antibiotics. I think the college should take a lead role in publicizing this idea,” she said.
Professor Julia Beatty, on the other hand, focuses on research in novel cancer-causing viruses of companion animals. She discovered the feline

hepatitis-B virus and gammaherpesvirus in feline animals, and strived to develop relevant vaccines. After serving as Hospital Director of the University of Sydney, Head of Small Animal Medicine and Associate Dean of Clinical Sciences, Professor Beatty will bring her years of teaching experience to the setup of JCC’s clinical teaching department.
Professor Beatty thinks this is an important mission, “Veterinarians do not only cure all kinds of complex diseases, but more importantly, they study these diseases in-depth through their research. Clinical science helps us understand animals and explore the transmission, diagnosis and treatment of those diseases. This knowledge is essential in the development of vaccines and for the advancement of the entire industry. I am grateful that the College has such a vision of training research professionals and putting resources in the field,” she said.
On top of the administrative work, Professor Beatty is also responsible for teaching. Education is her mission in life, a mandate that she sees as being “to help students connect the dots in learning”. She is dedicated to helping students integrate their knowledge by education. “When a student raises a research topic, it’s the teacher’s responsibility to guide them and stimulate their spirit of exploration,” she said.
Before CityU established its veterinary school, Hong Kong students had to pursue veterinary medicine studies in Australia. Some of these students have been taught by these two professors. Impressed with Hong Kong students’ diligence, intelligence and curiosity, Professor Barrs and Profesor Beatty look forward to lecturing CityU students. “Hong Kong students are full of curiosity, which is one of the requirements for being a veterinarian. Since animals cannot speak about their sickness, a veterinarian has to investigate the causes of the ailments, just like a detective,” said Professor Barrs.
Their word of advice for the students is this: “A good veterinarian is not only a doctor but a scientist. We hope that students at CityU can widen their horizons by taking further studies or careers overseas after graduation, and come back with international experiences and knowledge that can enrich the industry.”
賽馬會動物醫學及生命科學院作為全港首間獸 醫學院,一直致力吸納世界各地不同專長和背 景的專家學者,為香港以至亞太區培訓優秀的 獸醫及相關研究人才,合力應對人畜共患病、 抗藥性等威脅人類健康的公共衞生難題。今年, 學院就有幸邀得同在澳洲悉尼大學執教15年 的貓科權威學者,Vanessa Barrs教授及Julia Beatty教授加盟,分別出任學院的副院長兼獸 醫事務總監,以及動物醫學及傳染病講座教授。


兩位教授合作多年,問起何以雙雙決定加入城 大,她們不約而同說:「學院在亞太區擔當非 常重要的角色,而且匯集不同國籍的獸醫、研 究人員和科學家,各有專長和識見,若有幸參 與成為其中一員,令學院成為動物醫學的翹楚, 不單有挑戰性,而且意義重大。」
兩位教授執教15年,不單擁有豐富的教學經 驗,亦各有研究成就。Barrs教授研究真菌及病 毒引起的動物傳染病多年,在2013年發現新興 病原菌「貓曲霉」,會導致動物及人類感染侵 襲性曲霉病,並專注貓科動物的臨牀診斷和治 療方法。「一個出色獸醫不單只解決病徵,更 應探索疾病背後的各種病理,找出對症下藥的

防治之法,這就需要好奇心和求真求知的科學精神。」 她說。

Barrs教授表示,未來將專責學院的課程發展,確保課程 與國際接軌,「現今動物醫學不再只是一門獨立學科,而 是推動全球健康一體化(One Health)的重要學科,因為 抗藥性問題及登革熱、禽流感等威脅人類健康的人畜共患 病,需要獸醫、醫生及其他學科的研究專家群策群力,才 能妥善應對。因此,學院的課程亦應與時並進,為人類的 未來謀福祉。」她續說。
Barrs教授指現時香港禽畜業的豬場、魚場、雞場,以至 大大小小的動物收容中心,都是推動健康一體化的重要持 分者,「學院各方研究專才可為業界提供支援,我會帶領 學院團隊與他們緊密合作,改善業界的經營模式,從中推 廣動物福利。當動物身體健康,便能少用抗生素,這是重 要的宣傳教育工作,學院應在這方面擔任牽頭角色。」
至於Beatty教授多年來專注研究寵物的新型致癌病毒,首 次發現貓科動物的乙型肝炎病毒及伽瑪皰疹病毒,因而積 極研發相關疫苗。她曾在悉尼大學獸醫學院旗下醫院擔任 總監、小動物醫學部主管及臨牀科學部副院長,擁有豐富 的臨牀教學經驗,她將在賽馬會動物醫學及生命科學院成 立臨牀科學部門。
Beatty教授形容這項任務非常重要:「獸醫不只要醫治奇 難雜症,更重要的是背後的研究工作,臨牀科學可讓我們 更加了解動物,明白各類病症的傳播、診斷及治療方法, 有助研發相關疫苗,推動業界發展。我很高興學院有這樣 的遠見,才會一直培訓研究專才,並作出資源配合。」
Beatty教授不單負責領導行政工作,也不忘春風化雨的意 義,她視教育為人生使命:「To help students connect the dots in learning.」她矢志授業解惑、幫助學生融會貫 通,「當學生主動提出研究題目,老師應該循循善誘,激 發他們的探究精神。」Barrs教授說。
賽馬會動物醫學及生命科學院成立之前,香港學生要遠赴 澳洲攻讀獸醫學,當中不少亦是兩位教授的學生。在她們 眼中,香港學生勤力、聰明且好學,因此對教授城大學生 非常期待,「香港學生相當有好奇心,這正是做獸醫的必 備條件,皆因動物不懂言語,即使生病也無法表達,而獸 醫就好比偵探,要從動物的行為和習慣推敲驗證,了解牠 們患了甚麼病,再找出致病成因。」Barrs教授續說。 最後,她們不忘寄語學生:「出色的獸醫不只是一個好醫 生,更是一個科學家,希望我們的學生放開眼界,畢業後 多到外國深造或執業,汲取外國的經驗,將來回流香港, 將經驗和所學回饋業界。」


Professor Bruce Ransom, renowned American neurologist and an avid mineral collector, had planned to study geology. But when he accidentally stumbled into neurology back in his early days at the University of Minnesota, he came to see another path of life ahead of him.
As he recalled, “The brain is the most amazing part of human body, for it dictates how your arms and legs move, and how you develop a certain skill. Even if you had studied law all your life in the UK, you will find yourself facing a totally different legal system in China. That’s because these rules are created by humans. The brain, on the contrary, stays exactly the same regardless of race or nationality. I liked that absolute certainty – Holy smoke, I fell in love with it immediately!”
After obtaining his PhD degree in neurophysiology from the Washington University School of Medicine, Professor Ransom taught at Stanford University and Yale University. In 1995, he helped to found the Department of Neurology for the Washington University School of Medicine, with a faculty of 85 professors at its peak, where he worked as a professor for 24 years.
Having taught neurology at the Yale University and the University of Washington for years, Professor Ransom had students that came from around the world. In July, 2019, he embarked on a new chapter
in his life in Hong Kong by establishing a new Department of Neuroscience under the Jockey Club of Veterinary Medicine and Life Sciences (JCC). The new department will be developed based on JCC Department of Biomedical Science’s existing faculty, which has many neurologists from around the world.
“There are currently 8 to 9 neurologists at the Department of Biomedical Sciences, all of whom are outstanding, passionate and young scholars. Their remarkable profile was what made me accepted CityU’s invitation back then. Some of them will transfer to the new Department of Neurology while I will keep recruiting international experts. I expect we will have 20 to 25 faculty members.”
According to Professor Ransom, these scientists aren’t only focused on research. They are also educators who are dedicated to nurturing the young generation. They will join hands to design a unique neurology degree programme, which he expects will take 3 to 4 years. Master and PhD programmes in neurology will also be provided in the long run.
A veteran educator with more than half a century’s experience, Dr Ransom said it takes an institute sweat and blood to establish a new discipline. The key is the vision and mission of the university management. He recalled, “When I first discussed this project with CityU, I could feel everyone’s passion and dedication to bring this university forward. The president and the provost were very eager to build this new department. It was hard to resist.”
Professor Ransom used to teach neurology within a medical school, but CityU’s new neurology is under the only veterinary college in Hong Kong. He says it makes a lot of sense, “Animals also have a lot of neurological diseases which can infect humans. For example, the Eastern Equine Encephalitis virus and malaria can destroy human’s neurological systems. We should make One Heath a global fashion as animals health and human health are really interrelated,”
He is glad to share the same vision of promoting
One Health with CityU. The Jockey Club One Health Tower, which is due to open soon, will house not only the JCC, but classrooms and laboratories for neuroscience students. When asked about the qualities required for studying neurology, Professor Ransom answered with a smile:
“Neurology is a complicated discipline. You need to have the capacity to comprehend things in a very deep and detailed way in order to recognize that the brain is the most interesting body part. But don’t worry, we will design a truly fantastic curriculum that will make you think ‘Holy smoke, I fell in love with it immediately!’ as I did back then.”
美國神經學權威Bruce Ransom教授年輕時愛收集礦石, 因此曾經打算主修地質學,等到他升讀明尼蘇達州大學 後,一次無意之間接觸了神經學,他忽然發現人生另一道 曙光。
他回憶道:「大腦是人體最奧妙的部分,它掌管你怎樣協 調四肢、怎樣學會某個技能。你在英國讀了一輩子法律, 但到了中國卻是另一套法律系統,因為那是人為的規律。
但大腦的規律不同,大腦無分國界和種族,我喜歡那種絕 不含糊的確定性,天呀,我一瞬間就愛上!」
Ransom教授於70年代在美國華盛頓大學獲得神經學博
士學位後,曾在史丹福大學和耶魯大學任教多年。1995
年,他為華盛頓大學醫學院成立神經學系,高峰期有85 位教授,他擔任教授達24年之久,如今是該校的神經學 榮譽教授。
去年7月,他在香港展開人生新一頁,為賽馬會動物醫 學及生命科學院成立新的神經學系。所謂新學系早有一定 基礎,因為賽馬會動物醫學及生命科學院轄下的生物醫學 系,本已雲集來自不同國家的神經學專家。
「生物醫學系現有8、9位神經學家,都是首屈一指的年 輕學者,又躊躇滿志,我覺得這個班底很吸引,因此答應 城大的邀請。他們之中有些會轉職到新成立的神經學系, 我會再從世界各地招聘專家,令學系有20至25位教授。」
Ransom教授說這些人不單是埋首研究的科學家,也是作育 英才的教育家,共同為城大設計一個別出心裁的神經學學士 課程,他預計這個過程歷時三、四年,長遠還會提供神經學 碩士和博士課程。
他在教育界馳騁超過半個世紀,說創辦一個新學系要花盡心 血,關鍵是大學管理層的視野和眼界,他回憶:「我最初跟 城大磋商這個計劃時,我感受到每個人都充滿魄力,堅決要 令這間大學更上一層樓,校長和教務長都對開辦這個新學系 熱情洋溢,對我很有感召力。」
Ransom教授以前都是在醫學院教授神經學,城大的神經學 系卻隸屬香港唯一一所獸醫學院,他覺得是理所當然的事: 「動物也有很多神經疾病,而且可以影響人類,像中東腦炎 和瘧疾都可以經動物破壞人類的神經系統。動物和人類的健 康息息相關,因此我們應該推動『健康一體化』的教育。」
他慶幸城大跟他有相同的理念,以推動「健康一體化」為己 任。等到校園內的賽馬會健康一體化大樓落成時,既是動物 醫學及生命科學院的所在,也是神經學系學生的課室和實驗 室所在。問他修讀神經學系要具備甚麼條件,他笑笑口答:
「神經學是一門深奧的學科,你要有一種尋根問底的精神, 才能發掘大腦是一個多麼有趣的器官。放心,我們的學士課 程一定設計得精彩絕倫,令你對神經學一見鍾情,『天呀, 我一瞬間就愛上!』」就像我當年一樣。」


Dr. Daisuke Koyabu was born and grew up in Japan, although he also lived in the US for four years in Chicago and Cincinnati while as a child. He studied in Kyoto University, Japan and University of California, Berkeley for his bachelor’s degree and then received his PhD in Evolutionary Biology from the University of Tokyo. He had postdoctoral training at the Palaeontolological Museum, University of Zurich in Switzerland. Then, he was appointed as a Research Assistant Professor at University of Tokyo, then a tenured Associate Professor at Musashino Art University.
As an art lover himself, he very much enjoyed teaching comparative anatomy to and interacting with art-major students at Musashino, which is one of the leading art schools in the world. You may think anatomy is a basic subject in medical field, but it is also a very important subject for those working in the field of painting, sculpture,
illustrations, and 3D animations. Although he loved his relaxed job and once planned to stay at Musashino in Tokyo for the rest of his career, to pursuit a more challenging path as an educator and researcher he decided to come to Hong Kong and join the College of Veterinary Medicine and Life Sciences.
As a researcher, Dr. Koyabu focuses on the evolutionary and embryonic transformation of the cranial structure in vertebrates. In the field, he is recognized for the discovery of the “interparietal bone” in all mammalian groups and solving the homological problem of the mammalian skull (Koyabu et al., 2012 Proceedings of the National Academy of Sciences , Koyabu et al., 2014 Nature Communications ). Currently, he is particularly interested in understanding the body structure and development of bats whose whole body have undergone extreme evolutionary transformations.
生於日本的小藪大輔博士幼時居於美國芝加哥及辛辛那 提四年,後來回到日本成長。他於日本京都大學及柏克 萊加州大學修畢學士學位課程,再獲東京大學頒授進化 生物學博士學位,並於瑞士蘇黎世大學古生物學博物館 接受後博士培訓。他曾於東京大學任職研究助理教授, 後獲武藏野美術大學副教授的終身教席。
小藪大輔博士是藝術愛好者,享受跟武藏野美術大學主 修藝術的學生交流,向他們教授比較解剖學,該校是世 上首屈一指的藝術學府。有些人以為解剖學是醫學的基 本範疇,其實它對繪畫、雕塑、插圖和三維動畫專業亦 十分重要。雖然他很享受武藏野美術大學的寫意工作, 曾經打算以後也留在東京發展事業,但為了成為一位教 育家和研究員,他決定選擇一條更有挑戰性的路,就是 來港加入賽馬會動物醫學及生命科學院。
小藪大輔博士的研究重點是脊椎動物顱骨結構的進化和 胚胎轉化,發現哺乳類動物的「頂間骨」、解決了哺乳 類動物頭骨的同源問題(其合著論文曾刊於2012年《美 國國家科學院院刊》及2014年《自然通訊》),因此在 這個研究領域享負盛名。他最近鑽研蝙蝠的身體結構及 成長狀況,了解蝙蝠的極端進化過程。

介紹小藪大輔博士 比較解剖學副教授

Introducing our newly appointed Assistant Professor in Animal Behaviour and Welfare
Dr. Kai Liu
Dr. Kai Liu joined the Jockey Club College of Veterinary Medicine and Life Sciences in March 2019 as an Assistant Professor in Animal Welfare, Ethics and Behaviour. He contributes to the Bachelor of Veterinary Medicine by teaching courses of Animal Behaviour and Handling, Animal Welfare, and Livestock Husbandry.

Dr. Liu obtained his PhD degree in Agricultural and Biosystems Engineering from Iowa State University in the United States, and then joined the Swine Teaching and Research Centre at the School of Veterinary Medicine at University of Pennsylvania as a postdoctoral researcher. Over the past few years, Dr. Liu has been dedicated to applying engineering strategies and innovation to address global challenges related to food animal production, animal welfare, and sustainability. As you may know, to improve animal welfare, conventional cages for laying hens and individual crates for gestation sows have been banned in EU and several states in the United States. Instead, alternative housing systems, such as the enriched colony and cage-free aviary housing for laying hens and the group gestation pens for sows are increasing adopted by the global industry. However, with a larger number of animals housed in a larger colony or pen, several new welfare issues appeared, such as aggression. Aggression is very common issue
in the cage-free and crate-free housing systems which usually leads to massive sick or injured animals, and therefore causes deteriorated animal welfare and reduced production performance.
Therefore, Dr. Liu’s research mainly focuses on the areas of animal housing and facility and precision animal management, mostly for poultry and swine production in alternative housing systems. The results of his research projects have helped fill the important knowledge gaps related to alternative laying hen housing design and management and the decisionmaking in selection of lighting type for improved laying hen welfare, efficiency of resource utilization, and production performance. Currently, Dr. Liu is working on a project of developing an expert system for swine farm monitoring and management using computer vision and artificial intelligence. The project is to adapt and apply the state-of-the-art deep learning and computer vision techniques to monitor and assess behavior, health, welfare, production, and reproductivity of sows reared in alternative housing systems, both in large-group gestation pens and alternative farrowing systems. The overarching goal of this research project is to provide a viable solution to alter the way sows are managed on the farms, and ultimately improve welfare, health, production and reproductive performance of sows and therefore economic viability and sustainability of pork industry.
劉凱教授於2019年3月加入賽馬會動物醫學及生物科學院,擔任動 物福利、道德及行為助理教授。他教授多個獸醫學學士課程科目,包 括動物行為及處理學、動物福利學及畜牧業學。

劉博士於美國愛荷華州立大學獲得農業及生物系統工程學博士學位 後,加入賓夕法尼亞大學獸醫學院,於豬隻教研中心擔任後博士研究 員。劉博士多年來矢志以工程理念及創新意念解決世界不同問題,包 括動物食品生產、動物福利及永續發展。
眾所周知,歐盟及美國多個州份為了改善動物福利,禁止使用傳統飼 養母雞及母豬的雞籠和豬欄。世界各地的業界開始改用另一種禽畜 舍,以空間較大的圈舍取代本來安置母雞及母豬的籠子。不過,當禽 畜舍增加面積時,又會帶來其他福利問題,例如動物會互相攻擊,這 在寬敞的禽畜舍很常見,導致大型傷病,因而影響動物福利及動物的 生殖能力。
因此,劉博士的研究重點在於動物管理、動物圈舍及設施,研究以新 禽畜舍改善家禽及豬隻的生產。他的研究填埔了一個重要的知識領 域,包括新禽舍的設計及管理、燈光的選擇,從而改善母雞福利、資 源運用,以及動物生殖效率。
劉博士現正研發一個專業系統,以計算機思維及人工智能監管豬場。 這個項目利用先進的深度學習及計算機思維,監察及評估新禽畜舍的 行為及健康、福利及生產,以及母豬生殖率。這個研究項目的最終目 標是提供另一個解決方法,改變農場飼養母豬的方法,改善牠們的福 利、衛生、生產及生殖,最終提高養豬業的經濟效益及永續發展。
新任動物行為 及福利助理教授 劉凱教授 以新禽畜圈舍 改善動物福利
Centre for Applied One Health Research and PolicyAdvice
Centre for Animal Welfare Biomedical Research
Food Safety Research
CityU Veterinary Medical Centre
Jockey Club College of Veterinary Medicine and Life Sciences
Farm Extension Services Neurosciences
Continuing Professional Education
CityU Veterinary Diagnostic Laboratory